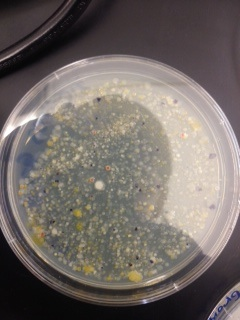
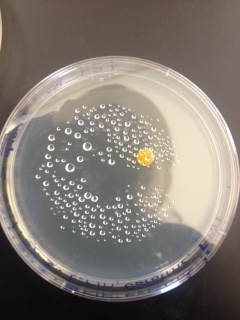

User:Erin McDonough/Notebook/Biology 210 at AU
Zebrafish, 3/5/15
Following the replacement of the control group on 2/23, at which point control and experimental groups seemed to display no morphological differences, the test group began to display morphological differences. When observed on 2/26, it appeared that the swim bladders of the fish were distended to the extent that the fins of the test group were pressed against their sides, in contrast to the control group's, which extended out from their sides. However, coloring, activity, and viability appeared undamaged in the test group. In fact, the test group maintained its numbers, all 6 of the original test group that survived hatching remained; however, only 9 fish in the control group had survived. Observation of the remains of a fish stuck to the top of the dish suggest that the fish's habitat may have been mechanically disrupted, possibly accounting for the large number of fish deaths in the control group.
Images: control group individual (top) shows normal sized abdomen, while test group individual (bottom) has a distended abdomen
Zebrafish were again observed on 3/2; 5 larvae from the test group remained. Larvae were generally inactive, however, no control larvae are alive to compare to. There was a single outlier in the test group that was active and responded to stimuli. The movement of this larvae generally consisted of bursts of movement. Eye diameter, which had been roughly equivalent in control and test groups on 2/23 was measure at about 200 micrometers on average. Movement in eyes was also slightly delayed, with the exception of the one outlier. Heartrate was at about ~90 bpm. Most notably, the larvae's swim bladders were still noticeably distended. The average length for larvae was about 4.5mm.
Upon returning to observe the zebrafish again on 3/4, no living larvae remained.
Zebrafish, 2/26/15
On Thursday, 2/19, 20 zebrafish eggs were placed in a petri dish with deerpark water (control group), while 20 were placed in a petri dish with 25 mg/L ethilhistoerone (test group). The eggs had been delivered the day before, and most appeared to be in the zygotic stage. The fish were checked the next day. Only 6 of the control group remained, while 10 of the test group remained. They were all still eggs. On Monday, 2/23, the fish were checked again, and the entire control group had died. 6 of the test group survived; 4 were already hatched, and were about 4mm long. 2 more of the test group hatched while under observation. 10 mL of water/estrogen were then removed, and replaced it with 25 mL of water/estrogen (respectively). The fish were also fed paramecium (1 drop/dish).
As the control group died, they were replaced with 20 new fish from a bowl containing water. There were no morphological differences observed between these fish and the test group.
4.7.15 Including a data table or a clearer way or presenting data would be helpful. SK
--Erin McDonough 11:52, 26 February 2015 (EST)
16S rRNA gene Results, 3/11/15
Samples 1 and 4, which were run on agarose electrophoresis gel last week and then sent out for sequencing, returned the following sequences, in which N represents unidentified base pairs.
Sample 1: TGNANGCCNANCGNGTNAGANGANCGNNNTNCTGNGGNANNCTNTGNGNNAGCGNGNTGATACGGGTGCGGAACACGTGTGCAA CCTGCCTTTATCAGGGGGATAGCCTTTCGAAAGGAAGATTAATACCCCATAATATATTGAATGGCATCATTTGATATTGAAAACTCCGGTGGATA GAGATGGGCACGCGCAAGATTAGATAGTTGGTAGGGTAACGGCCTACCAAGTCAGTGATCTTTAGGGGGCCTGAGAGGGTGATCCCCCACACTG GTACTGAGACACGGACCAGACTCCTACGGGAGGCAGCAGTGAGGAATATTGGACAATGGGTGAGAGCCTGATCCAGCCATCCCGCGTGAAGGAC GACGGCCCTATGGGTTGTAAACTTCTTTTGTATAGGGATAAACCTTTCCACGTGTGGAAAGCTGAAGGTACTATACGAATAAGCACCGGCTAACT CCGTGCCAGCAGCCGCGGTAATACGGAGGGTGCAAGCGTTATCCGGATTTATTGGGTTTAAAGGGTCCGTAGGCGGATCTGTAAGTCAGTGGTGA AATCTCATAGCTTAACTATGAAACTGCCATTGATACTGCAGGTCTTGAGTAAAGTANAAGTGGCTGGAATAANTAGTGTANCGGTGAAATGCATAG ATATTACTTANNAACACCAATTGCGAAGGGCAGGTCNCTATGTTTTAACTGACGCTGATGGACGAAAGCGTGGGGAGCGAACAGGATTANATACC CTGGTNGTNNNNGCCGTANACGATGCTNACTCNTTTTTNGNNCTTCNGATTCAGAGACTAAGCNAAANTGATAGTTAGNCNNCCTGGNGAGTNC NTTCNCAANAATGAAACTCANAAGAANTGACGGGGGNCCCNCNCANCCGTGNATTATGTNGTTTAATTCANNNNNCNNNNGNANCCTTNNCNAC GCTTAANNGGGATTGNGGGGGNTTAGANNNNANNNGTCTCNNCATTTCNANNTTCTNCNNGGGNNGNCGGNGGNTGGTCCCCCNNTGTANGNN NNGGTCAAGNACNNGNNGNNCCCNNT
Sample 4: GCAGTCNAGCGGATGANANNAGCTTGCTCTTCGATTCAGCGGCGGANGGGTGAGTAATGCCTAGGAATCTGCCTATTAGTGGGGG ACAACGTTTCGAAAGGAACGCTAATACCGCATACGTCCTACGGGAGAAAGCAGGGGACCTTCGGGCCTTGCGCTAATAGATGAGCCTAGGTCG GATTAGCTAGTTGGTGAGGTAATGGCTCACCAAGGCGACGATCCGTAACTGGTCTGAGAGGATGATCAGTCACACTGGAACTGAGACACGGTC CAGACTCCTACGGGAGGCAGCAGTGGGGAATATTGGACAATGGGCGAAAGCCTGATCCAGCCATGCCGCGTGTGTGAAGAAGGTCTTCGGATT GTAAAGCACTTTAAGTTGGGAGGAAGGGTTGTAGATTAATACTCTGCAATTTTGACGTTACCGACAGAATAANCACCGGCTAACTCTGTGCCAN CAGCCGCGGTAATACAGAGGGTGCAAGCGTTAATCGGAATTACTGGGCGTAAAGCGCGCGTAGGTGGTTCNTTAAGTTNNATGTGAAATCCCC NGGCTCNACCTGNNAGCTNCNTTCNANACTGTCNNGCTANANTATGGTANANGGTGCTGGAATTTCCTCTGTNGNNNNNCAAATNNNNANAT ANANNATTGAACNNNNNTGNCNANNNGNNNNCCTCCNCTGNTNGNCNANNCNNGTATNCGCNCCNTGNGNGNGAAACACNNGNGGNTNGN CTCCNNCGCCACNGNGTNTNCNANATNTACNANCCTTTTCGNTGNGNTNNNNNNNTATTNCNCNGNCTCNCCNNANANNTNNACNNNCANN NTNNNGNNNNGNCCNCCCTGGGGGCTCNNCNNGNNTTTTTNNNTGNCNNGNGCAAGNAANNNNNGNGGGNGTTGNNGCTNNNTNNNACAA AANNANNNNANCGCCCCNTGGTNNNGNNCNGGNNNANGGNNNNTAANANNTGGNNTGGNNNCCTNCGGGNACCNAAANNNNNGGNNGNA NNGNANNNCNNNNNCTCCCNNNCCNANNNNGGTTGG
Sample 1 was considerably more definitive than Sample 4, which ultimately could only be fit to a best match of 59% due to the large number of unidentified base pairs. The table below presents the findings when each sample was run through the GeneWiz and Genomic Blast programs.
| Sample # | Number of base pairs | Identity of Bacteria | % match? |
| Sample 2 | 1386 | Chryseobacterium sp. WR1 | 80% |
| Sample 3 | 1397 | Pseudomonas sp. Ata11 | 59% |
Sample 1 was identified as Chryseobacterium with an 80% match to the known genetic code. Chryseobacterium is gram-negative, rod-shaped, and yellow-pigmented. It is found in environments much like that of this transect, including in soil, plants, and wastewater. This sample had been characterized under the microscope as coccus-shaped, gram positive, and orange-yellow in color. As the color matches, and sample is matched relatively well to the known genetic code, it is likely that this sample is indeed Chryseobacterium, and that some error was involved both in observing the shape of the bacteria under the microscope (identification is difficult for such small organisms without use of an electron microscope) and in the gram stain procedure.
Sample 4 was identified with less certainty (59%) as Pseudomonas. Pseudomonas are gram-negative and rod-shaped. As this sample was characterized under the microscope as rod-shaped but gram-positive, and the percent match to the known genetic code is so low, it is likely that this is not a correct identification of this bacteria.
2.20.15 Excellent entry. Good description of Berlese funnel methods and invertebrates found. Attractive food web. SK
Lab 5: Animal Species 2/18/15
Purpose: For this lab, various animal species who either make their home in the transect or pass through the transect were studied. Smaller invertebrates were collected using a Berlese Funnel and studied under a microscope, while larger vertebrates were merely observed for their presence in the transect.
Materials and Methods: Last week, leaf litter, consisting of oak tree leaves and dirt, was collected from the transect and placed in a glass funnel with a screen inside it to prevent leaves or other debris from falling through the funnel. The base of this funnel was then attached to a 50 mL tube containing about 25 mL of 50% ethanol and 50% water by means of parafilm. This was attached to a ring stand and placed under a lighted 40 watt lamp, roughly 6 inches from the top of the litter. Everything was covered with foil, and let sit for one week. This week, the contents of the 50 mL tube were placed in small petri dishes, and observed under a microscope. The specimens gathered via the Berlese Funnels of other groups studying the same transect were also examined under a microscope. The transect was also observed for the presence of vertebrates.
Observations: The most prevalent invertebrates species by far was the Springtail X, ranging in size from 3 to 5 mm in length, of which 6 were collected by this group via the Berlese Funnel. One immature Springtail, attached to the back of an adult Springtail, was also found; it was about 0.5 mm in length. No other species were found by this lab group. Large numbers of Springtails were also found by other groups studying the same transect; one specimen of one species was also found. Findings are summarized in the chart below:
| Organism | Length | Number of Samples | Description of Organism |
| Springtail X (found by this lab group) | 3 - 5 mm | 6 | White. Long, narrow body segmented similarly to an insect’s with what might be identified as head, thorax, and abdomen; thorax is further segmented into 3 parts. 6 appendages, plus 2 antennae. Long, forked tail. Mandible-like mouth. |
| Springtail X (found by other lab groups) | 3 - 5 mm | 4 | Match description above |
| Immature Springtail | 0.5 mm | 1 | Match description above on a smaller scale; attached by its back to the back of a mature springtail. |
| Psocoptera—plant lice (found by another lab group) | 4 mm | 1 | More circularly proportioned body; 6 appendages plus opaque wings. Mandible at mouth. |
Image of Springtails (including immature Springtail):
5 vertebrate species were also noted to pass through the transect: black and brown squirrels (Sciurus carolinensis and Sciurus carolinensis), common field Sparrows and American tree sparrows (Spizella pusilla and Spizella arborea), and a cottontail rabbit (Sylvilagus floridanus). While none of these species have made the transect their home in terms of living within the transect exclusively or nesting within the transect, all five species pass through the transect with great enough frequency to determine that it is a part of their larger niche.
Discussion: The transect did not yield a great variety of invertebrate species. Instead, it seems that it provides a niche in which Springtails particularly thrive, particularly during the winter months. It is possible that the transect is home to a greater variety of species in warmer months, when more plant life grows in the transect. In terms of vertebrates, squirrels and sparrows likely frequent the area due to its proximity to a large oak tree, which not only provides shelter, but also acorns in the fall. The bushes of the transect may also be attractive cover for the squirrels, as well as rabbits, as the surrounding area is largely open lawn. The surrounding lawn itself may be a good place to forage for food, not only for food like acorn and seeds, but also for discarded food and crumbs left by students; both sparrows and squirrels are known to readily consume discarded human food products. Rabbits may be especially attracted to the transect as the long grass and rose petals within are edible for them.
Below is a food web that connects the various organisms within the transect to each other:
This web is obviously incomplete, as many species that either live within or pass through the transect were likely not identified, especially as the samples for this lab were collected during the winter. However, it does provide visualization of some of the basic connections between the organisms within the transect. These organisms form a community in which all organisms, even those not connected on the web, do influence each other by their presence. Plant life, as well as some algae, are at lower trophic levels, while protists, invertebrates, and vertebrates occupy higher trophic levels. The carrying capacity of this transect can be understood relative to trophic levels. The transect has a fairly large carrying capacity for primary producers, relative to its size; many different plants and algae flourish, even in the winter. Smaller creatures, like invertebrates, bacteria, and protists also seem to do quite well in this transect. However, the transect is too small to support larger animals that occupy higher trophic levels; vertebrates only pass through the transect, or occupy it as part of a larger niche.
--Erin McDonough 23:59, 18 February 2015 (EST)
2.20.15 Excellent notebook entry. SK
Lab 4: Plantae and Fungi, 2/11/15 Purpose:
The purpose of this lab was to study plant and fungi samples from the transect. Five samples were studied and characterized in terms of vascularization, specialized structures, and mechanism of reproduction. While relatively small samples were taken of each plant, the size and structure of the plants from which the samples were also considered in characterizing the samples.
Materials and Methods:
A representative sample was taken from each of five plants, and brought back to the lab in a ziplock bag. Not all samples were of living plants. Sample 1 was a dead bud taken from the rose bushes (currently dormant) along the west edge of the transect. Sample 2 was a blade of the long grass that grows beneath the rose bushes, and was the first of three living samples (samples 3 and 4 were also taken from non-dormant plants). Samples 3 and 4 were previously unidentified low-lying weeds growing along the edge where the planter borders with the grass. Sample 5 was an oak leaf, also taken from along the edge of the planter, where many oak leaves had piled. Although the oak tree itself is not part of the transect, it does have a significant impact on the transect, overshadowing and dropping leaves into the transect, and was therefore considered worth characterizing as part of the study of the transect. A sample from the bushes in the north corner, described in Lab 1, could not be taken, as these plants had been trimmed down to the ground for the winter, and taking a sample would have been damaging to the plant. No seeds could be found for any plants within the transect. The five samples taken were examined under a microscope in the laboratory.
Left: Images of Samples 1-5, from left to right, respectively; Middle: Oak Tree; Right: Rose Bush
Observations:
Sample 1, Rose Bush: This sample was taken from a rose bush about 2 cubic feet in size with a woody stem and primary branches. The presence of differentiation of roots, trunk, branches, leaves, and buds on the plant demonstrates the greatest amount of specialization of structures of any of the plants in the transect. Leaves were broad, tear-shaped, with serrated edges and oppositely paired primary veins; leaves were parred opposite each other on the branch. The presence of multiple buds on the plant identifies the bush as an angiosperm. The sample itself was a dead bud, 3.5 cm long. Examination of the exterior of the bud showed five petals arranged around a stigma. Cutting the bud open, two cotyledon could be seen. Vascularization could not be determined through examination, as the sample was dead, but given the other aspects of the plant, it can be identified as a dicot, and therefore its vascularization likely followed the dicot patter of vascular bundles in a ring. Genus: Rosa.
Sample 2, Long Grass: This sample was taken from a clump of ornamental grasses, the individual blades of grass stemming from a single root complex. The blades were lying flat against the ground, covering about 50 square cm. The sample itself was 30 cm in length. The blade-like leaves of the plant were about 2 cm in width, and exhibited parallel veins. The plant was not flowering, but as all ornamental grasses are angiosperms, it can be determined that the plant does flower. While lacking a stem-and-branch structure, this plant is still relatively specialized, with roots, leaves, and presumably flowers seasonally. The vascularization of the plant is of scattered bundles. Judging by the structure of the leaves, the plant is likely a monocot. Genus: Likely Carex. Due to the great variety of ornamental grasses, the genus of this plant could not be definitely determined, but it is of the family Graminae.
Sample 3, Weed #1: This sample was of an entire plant (not including roots) which was about 8 cm tall, and stood upright in the planter of the transect. The plant's stem soft, not woody like the rose bush; however, it did demonstrate a significant amount of specialization, with roots, stem, and opposite branching leaves. The plant is known to flower, making it an angiosperm. The leaves were rounded, 2–3 cm diameter, with lobed margins and network veins. Upon cutting open the stem, vascularization, appeared to follow the pattern of bundles in a ring, likely placing the plant as a dicot. Genus: Lamium.
Sample 4, Weed #2: This sample was of an entire plant, including roots. The plant is 11 cm from root to tip, with 6 cm above the ground; however, this plant's structure is such that its leaves actually lie fairly flat to the ground. The plant has long, relatively thin (3-4 cm) leaves, blade-like, with scalloped edges. Each leaf has a single primary vein, with a network of smaller veins, not arranged in any particular pattern. Vascularization is that of scattered bundles. It is difficult to identify this plant as monocot or dicot, as it exhibits traits of both groups, and is not currently flowering, although it is an angiosperm. Difficulty to definitively identify, but likely Hypochoeris radicata.
Sample 5, Oak: The final sample was a dead leaf fallen into the transect from a nearby oak tree, estimated to be between 50 and 60 ft in height. The sample was 11.5 cm in size, and had a central vein with opposite branching veins. The oak tree can be identified as a dicot angiosperm with considerable specialization (equal to that of the rose bush). Genus: Quercus.
Findings summarized in table below:
| Transect Sample Plants | Location | Description (Size & Shape) | Vascularization | Specialized Structures | Mechanism of Reproduction |
| #1: Rose Bush (Rosa) | West edge | 2 cubic feet, roughly spherical | Network of branching veins in leaves, bundles in a ring assumed as dicot | Roots, trunk, branches, leaves, buds | Dicot Angiosperm |
| #2: Ornamental Grass (Graminae) | Beneath rose bushes; west edge | Low to ground, covering 50 square cm. | Parallel veins, vascular bundles scattered | Roots, leaves, assumed flowering | Monocot Angiosperm |
| #3: Weed 1 (Lamium) | Border of planter and grass | 8 cm, upright, with opposite branching leaves off stem. | Network of veins, vascular bundles in a ring | Roots, stem, leaves, known flowering | Dicot Angiosperm |
| #4: Weed 2 (Hypochoeris radicata) | Border of planter and grass | Low to ground, with 6 cm spear-shaped leaves. | Central vein with non-branching network, vascular bundles scattered | Roots, leaves, assumed flowering | Angiosperm (unknown dicot or monocot) |
| #5: Oak (Quercus) | Tree is outside of transect (East side); sample taken from border of planter and grass | Estimated 50-60 ft tall, with main trunk branching in two about halfway up. | Network of branching veins in leaves, bundles in ring assumed as dicot. | Roots, trunk, branches, leaves, known flowering (buds/acorns) | Dicot Angiosperm |
For Further Study:
A leaf litter sample, containing dead leaves (largely from the oak tree) and soil from the planter was gathered in a ziplock bag. The leaf litter was placed in a funnel with a screen at the bottom, preventing any of the litter from falling through the filter. The bottom of the funnel was then attached using parafilm to a 50 mL conical tube containing 25 mL of 50:50 ethanol/water solution. This structure was then set up on a ring stand under a lighted 40 watt lamp with an incandescent bulb, about 1-2 inches from the top of the leaf litter. This setup was then covered in foil and let sit for 1 week. Invertebrates will be collected and examined from this Berlese Funnel next week.
Additionally, the 16S rRNA gene that was amplified during last week's lab was run through electrophoresis, and samples 1 and 4 were determined to be the best 2 samples of DNA. These were sent out for sequencing in order to identify the bacteria.
--Erin McDonough 02:07, 12 February 2015 (EST)
2.10.15 Very good notebook entry. Could include more detail on gram stain procedure or a link or reference to a protocol used. Using a table to present colony number results may have made it more clear. Try http://excel2wiki.net to convert excel to OWW tables. SK
Lab 3: Bacteria Cultures, 2/5/15
Purpose: The purpose of this lab was to study what bacteria that could be found in the transect. As bacteria are generally too small and difficult to find within a Hay Infusion Culture, samples were taken from the Hay Infusion last week and grown on nutrient agar dishes. Bacteria were plated on dishes with and without tetracycline, in order to study which bacteria were antibiotic resistant, and how the presence of tetracycline would affect the overall growth of bacteria colonies.
Materials & Methods: In the previous lab, the Hay Infusion was mixed, and a 100 microliters sample was taken 10 mL of broth to make a 1:100 dilution. Serial dilution was then performed to make 10^-4, 10^-6, and 10^-8 dilutions. 100 microliters of each of these dilutions was pipetted onto an agar petri dish and spread to form 10^-3, 10^-5, 10^-7, and 10^-9 dilutions. This process was repeated on four nutrient agar petri dishes containing tetracycline. This week, these dishes were first examined on the macroscopic scale and then at the microscopic scale. Macroscopic observations included number, shape, and color of the colonies, and how colony growth was affected by the presence of tetracycline. Microscopically, bacteria were examined first using a simple wet mount, and then again after being gram stained. Four different samples were examined; two from an agar nutrient plate, and 2 from tetracycline plates. Samples 1 and 2 were taken from different colonies on the 10^-7 dilution nutrient agar dish, sample 3 was taken from the 10^-3 tetracycline dish, and sample 4 was taken from the 10^-5 tetracycline dish.
Macroscopic Observation: There were far more bacteria colonies on the 10^-3 nutrient agar dish, with over 1000 colonies. This plate also demonstrated the most bacterial diversity, with bacteria of at least 5 distinct colors. This plate also contained algae. However, the bacteria on this plate also formed the smallest colonies, none of which reached even 0.5cm in length. Bacterial colonies on plates were there were fewer colonies present, such as the other nutrient agar plates, were much larger, measuring 0.5 to 1.0 cm in length. None of the other plates showed similar diversity of bacteria. The tetracycline plates contained fewer and less diverse bacteria for plates of similar dilutions.
Bacteria plates, from left to right, nutrient agar plates of increasing dilution, followed by tetracycline plates of increasing dilution:
Number of colonies--Plate 1: >1000, Plate 2: 85, Plate 3: 6, Plate 4: 0, Plate 5: 250, Plate 6: 8, Plate 7: 1, Plate 8: 0
Microscopic Observation: Sample 1 was taken from a cream colored, circular undulate convex colony 0.5cm in length on the 10^-7 agar nutrient plate. Cells observed from this colony appeared to be bacillus with flagellum, and were gram positive. Sample 2 was taken from a white, circular entire convex colony 1.0 cm in length on the 10^-7 agar nutrient plate. Cells observed were coccus and gram positive. Sample 3 was taken from a orange, circular undulate convex colony 0.6cm in length on the 10^-3 tetracycline plate. Cells were coccus and gram negative. Sample 4 was taken from a yellow, circular entire convex colony 0.7cm in length on the 10^-5 tetracycline plate. These bacteria were coccus and gram positive.
Discussion: As anticipated, more bacteria (both in terms of numbers and diversity) grew on the nutrient agar plates than on the plates with tetracycline. More bacteria also grew on plates were more concentrated dilutions were used. However, where there were fewer bacteria, the colonies of those bacteria that persisted tended to be much larger, likely due to the absence of competition. Only two different types of bacteria seemed to thrive on the tetracycline plates. The orange bacteria from which sample 3 was taken did particularly well. Notably, this bacteria was the only one examined that was gram negative. Tetracyclines inhibit protein synthesis by preventing the attachment of aminoacyl-tRNA to the ribosomal acceptor site, and work against both gram-positive and gram-negative bacteria, so it is unclear whether sample 3's resistance to the antibiotic is related to it's gram-negative character. Tetracycline also works against other organisms outside of bacteria, which may account for the presence of fungi in the agar nutrient dish but not the tetracycline dish.
For further study, the DNA from the four bacteria was isolated using PCR. The 16S rRNA gene was selectively amplified, and will be used next week.
Sources: Chopra & Roberts, "Tetracycline Antibiotics: Mode of Action, Applications, Molecular Biology, and Epidemiology of Bacterial Resistance" in Microbiology Molecular Biology Review, June 2001. http://www.ncbi.nlm.nih.gov/pmc/articles/PMC99026/
--Erin McDonough 10:58, 5 February 2015 (EST)
2.4.15 Excellent notebook entry. Lots of good detailed description of protists and Hay infusion. Well organized and some obvious thought was put into it. SK
Lab 2: Hay Infusion Culture, 1/28/15
Observation of Hay Infusion: In this lab, the Hay Infusion Culture prepared in the previous lab was examined, and samples were taken for microscopic observation. The jar was filled with murky brown liquid, with silt-like matter having separated and sunk to the bottom of the jar, and some larger structures, primarily leaves, suspended in the mixture. The surface was covered in a thin film, and close to the center a small leaf touched the surface; around this leaf a white substance had formed. The mixture smelled faintly swampy. Sample 1 was taken from the surface of the Hay Infusion, close to leaf protruding at the surface, while Sample 2 was taken from matter at the bottom of the jar. Sample 1 therefore came from a niche which provided infrastructure on which organisms might live, while sample 2 was taken from an area where swimming organisms might be expected.
Microscopic Observation: Wet mounts were made of the two samples, and observed under the microscope; protozoa were the primary organisms identified, although some organisms that were likely bacteria were also noted. In sample 1, three protozoa were identified: colpidium (70 micrometers), pandorina (65 miocrometers), and amoeba (300 micrometers). A large number of rapidly moving organisms 1-2 micrometers in size were also noted and presumed to be spirillum bacteria. Sample 2 contained pandorina (35 micormeters), colpidium (70 micrometers), and paramecium (125 micrometers). In both samples, the colpidium were very fast-moving. The paramecium was also fast moving, while the amoeba moved through slow extension of "legs." The pandorina in both samples were motile, but did not move much; in sample one, the pandorina was bound on all sides by leaf matter, and spun in place, while in sample 2 the pandorina did not exhibit much motion at all.
Drawings of Protozoa Viewed in Samples 1&2:
Meeting the Needs for Life: All of these organisms meet the needs of life: all consist of cells, process information, acquire and use energy, and replicate and evolve as species. The observed bacteria appeared to be unicellular, while the colpidium, pandorina, amoeba, and paramecium were all multicellular organisms. All organisms observed moved, suggesting that they were able to acquire and use energy. Additionally, the movement of the various organisms observed appeared to correspond with environmental factors, such as the presence of other organisms or inorganic matter, suggesting that these organisms are indeed processing information (in addition to passing on information through DNA replication). Although replication was not observed during this lab, and evolution cannot be observed in individuals, all the organisms identified are known to replicate and evolve as species.
Ideas for Further Study: Following inspection of the samples from the Hay Infusion Culture, the culture was mixed and the mixture used to inoculate 4 agar nutrient plates and 4 tetracycline plates. If the Hay Infusion were allowed to sit for 2 months, it is likely that more differences would be noted in samples taken from diverse parts of the culture. While sampling after one week showed copidium and pandorina, both highly motile organisms, in both samples, it is likely that after 2 months niches that provide more structure, such as the niche from which sample 1 was taken, would exhibit more organisms like amoeba, with organisms that are more adept swimmers dominating niches like that of sample 2.
--Erin McDonough 09:02, 29 January 2015 (EST)
1.27.15 Excellent first entry. Could include headings: Purpose, Materials & Methods etc. SK
Lab 1: Transect Observation and Sample Taking, 1/26/15
The transect under observation for this lab was a roughly 20 by 20 meter trapezoidal plot, in the middle of the Eric Friedheim Quadrangle at American University; as such, this transect is often traversed, possibly even more so than other parts of the quad, as it lies right next to a path, which forms the southwest border of the plot. From this transect, a sample including both organic and inorganic matter was taken, from which a Hay Infusion Culture was created.
The transect's chief abiotic components include dirt, which forms a planter along the west edge of the transect, patches of ice and snow, and a stone and concrete wall that protrudes into the north-most corner of the transect. A plastic fork was also found just outside the eastern bounds of the transect, suggesting that trash cast aside by students may regularly be cast into the transect. Chief biotic components include rose bushes in the planter along the west edge of the transect, long grass planted beneath them, and another set of bushes (which also flower during warmer months) around the concrete and stone wall in the north corner; both sets of bushes have few, brown leaves, almost as though dead; however, both are perennials and therefore will likely become fuller with the return of warmer weather. Underneath these plants there are many dead leaves, particularly piled up along the edge where the planter meets the grass; these come from a large oak tree that overshadows the transect (east of the transect). Within the planter are also small sticks, wood-chips that appear to be left-over from when the planter was last mulched, and a variety of weeds. The rest of the plot, which forms the majority of the transect, is covered in short grass, with a few weeds interspersed; the grass is currently rather patchy, likely from a combination of trampling and recent weather, which has been cold and icy. The soil throughout the transect is damp. The transect is largely flat, with the planter slightly elevated above the surrounding grass.
The sample to be used for the Hay Infusion culture was taken primarily from the border between the planter and the grass, near the rose bushes, as indicated on the drawing below. The sample included dirt, dead leaves from the oak tree, grass, weeds, and leaves from the rose bush (including one thorn). A long grass from further beneath the rose bushes was also included in the sample, as well as leaves from the dead plants in the north corner. 12 grams of the sample were placed in a plastic jar, along with 500 mL of deerpark water and 0.1 gm dried milk, the lid was put on the jar, and the sample was gently mixed for about 10 seconds. The lid was then removed and the jar was placed on a table in the lab to incubate for 1 week.
Drawing of an Aerial View of Transect:
--Erin McDonough 22:59, 26 January 2015 (EST)
First entry, 1/22/15
Testing